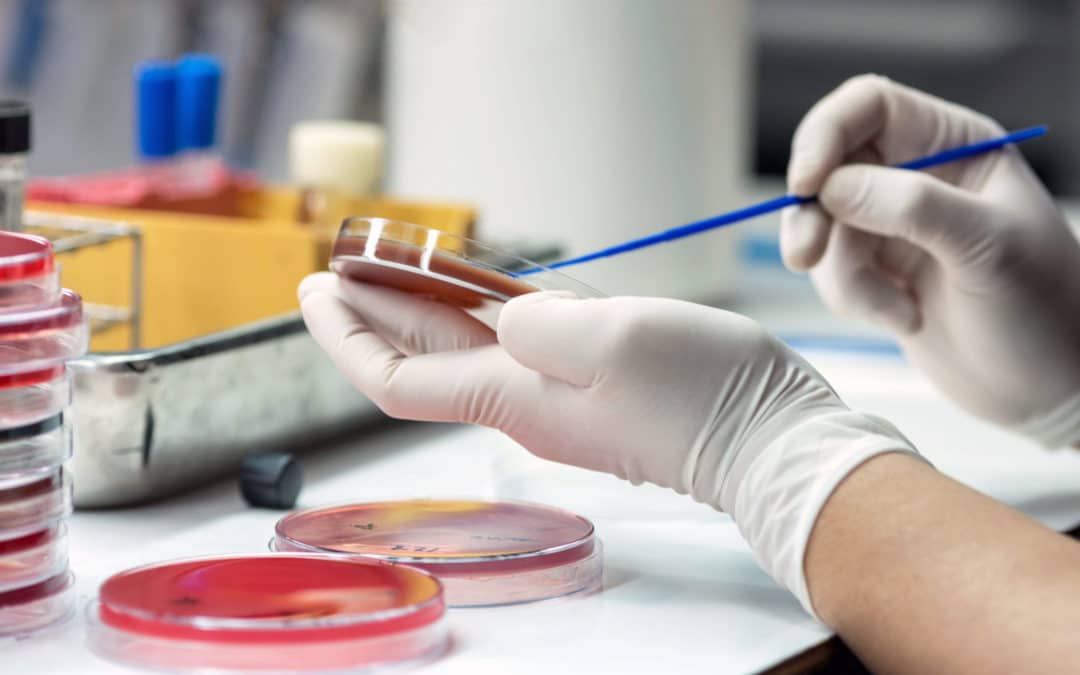
Antibiotic incentives in the revision of the EU pharmaceutical legislation

by European Public Health Alliance | Sep 23, 2022 | Statements
In September 2022, the European Public Health Association published a joint statement co-signed by several health NGOs, including EPHA. The purpose of this letter is to address the health emergency preparedness, learn from the pandemic, and improve the general...

by European Public Health Alliance | Sep 7, 2022 | Opinion
Thanks to the European Parliament Special Committee on the COVID-19 pandemic for this opportunity to share our feedback. We believe that meaningful engagement with civil society is key to strengthen democratic processes and improve policymaking. The European Public...

by European Public Health Alliance | Aug 29, 2022 | Opinion
Guest article by Robin Doeswijk and Gauthier Quinonez, European Hematology Association Plasma Shortages Plasma-derived medicinal products (PDMPs) are used to treat various rare, chronic, and potentially life-threatening conditions including immune deficiencies,...

by European Public Health Alliance | Jul 14, 2022 | Position & Policy Papers
In its current revision of the EU pharmaceutical legislation, the European Commission (EC) plans to address the increasing burden of antibiotic resistance (AMR) by setting up incentives for the development of new antibiotics. With increasing antimicrobial...

by European Public Health Alliance | Jun 30, 2022 | Opinion
“With HERA up and running, the EU has significantly reinforced its capacity to respond and address new health threats decisively”. This is what Health Commissioner Stella Kyriakides said on 28 June 2022 when she announced that the first batch of monkeypox vaccines...